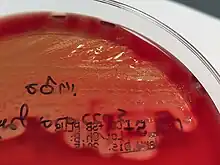

Gourme
La gourme, aussi appelée angine du cheval, est une maladie contagieuse des équidés, causée par la bactérie Streptococcus equi equi[1]. Elle atteint généralement les équidés de moins de 5 ans. Il existe un vaccin préventif à injection labiale.
Streptococcus equi sur milieu de culture.
Symptômes
- Baisse d'appétit ;
- Rejet nasal séreux, d'abord muqueux, puis purulent ;
- Gêne respiratoire ;
- Gorge douloureuse, présence d'œdèmes douloureux au niveau des poches gutturales ;
- Gonflement des ganglions lymphatiques sous-maxillaires, voire parfois rétropharyngiens et sous-parotidiens, puis présence d'abcès ;
- Évolution chronique possible et formation d'abcès de localisations variables, notamment intraabdominaux.
Évolution de la maladie
La gourme évolue en quatre phases. Les symptômes se manifestent de 3 à 14 jours après la contamination.
- Dans un premier temps, l'animal présente des signes d'abattement : fièvre, jetage séreux, inappétance ;
- Rhinite et pharyngite : jetage de séreux à purulent, toux humide, laryngites, pharyngite (douleur !) ;
- Lymphadénite régionnale : Abcès ganglionaires, douleurs du larynx toujours présentes, difficulté respiratoire peuvent apparaitre.
- Maturation des abcès : Rupture et écoulement de pus (substance contagieuse !)
Complications possibles :
- Abcès métastatiques (poumons, foie, rate, reins...) ;
- Purpura hémoragique ;
- Myopathie ;
- Emphysème des poches gutturales.
Notes et références
- Portail équestre
- Portail de la médecine vétérinaire
Cet article est issu de Wikipedia. Le texte est sous licence Creative Commons – Attribution – Partage à l’identique. Des conditions supplémentaires peuvent s’appliquer aux fichiers multimédias.